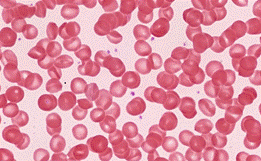
ОГЭ по биологии

Все варианты задания 22 из открытого банка заданий ФИПИ к ОГЭ по биологии с ответами: применение биологии. Задания с развернутым ответом.
Все варианты задания 22 с ФИПИ к ОГЭ по биологии
Человек и его здоровье
Дайте развернутый ответ.
Объект, изображённый на рисунках, вызывает инфекционное заболевание у человека. Что это за объект? Каким путём происходит передача инфекции от человека к человеку?

Ответ:
1. Это вирус иммунодефицита человека (ВИЧ).
2. Парентеральный путь (через кровь) — заражение происходит при инъекционном введении инфицированных наркотических веществ, использовании нестерильных игл и шприцев, при переливании зараженной крови, через необеззараженные инструменты для гигиенических процедур.
Половой путь - заражение происходит при половом контакте с ВИЧ-инфицированным
Вертикальный, или внутриутробный путь - вирус передается от инфицированной матери ребенку во время беременности, родов, кормления грудью.
Номер: 978A74
Дайте развернутый ответ.
Рассмотрите рисунок, иллюстрирующий приём первой помощи. Назовите вид травмы, при котором используют этот приём. Назовите приём и объясните его значение.

Ответ:
1. Перелом костей конечностей (в данном случае ноги)
2. Наложение шины. Шина помогает зафиксировать и обездвижить конечность, чтобы не дать сместиться тканям, чтобы острые края кости не нанесли еще большую травму при транспортировке пострадавшего.
Номер: 15FA44
Дайте развернутый ответ.
Рассмотрите рисунки, на которых изображены травмированная нога, место травмы и одна из мер первой помощи. Назовите травму и объясните, почему охлаждение помогает снять отёк.

Ответ:
1. Растяжение связок.
2. Охлаждение зоны повреждения способствует развитию анальгетического, противоотечного, спазмолитического, противовоспалительного, гемостатического (кровоостанавливающего) эффектов. Охлаждение вызывает сужение кровеносных сосудов и, как следствие, снижение кровотока, снижает тканевой метаболизм, потребление кислорода, отек и воспаление.
Номер: 19024B
Дайте развернутый ответ.
Рассмотрите рисунки, иллюстрирующие этапы оказания первой помощи. Как называют изображённую манипуляцию? Укажите два правила оказания данного вида первой помощи.

Ответ:
1. Наложение жгута
2. Жгут накладывают выше места раны.
После наложения жгута нужно указать на нем дату и время наложения.
Номер: DB5F44
Дайте развернутый ответ.
Рассмотрите рисунок, на котором изображена спина человека с изменённой формой позвоночника. Как называют такое изменение? Укажите одну из причин соответствующего заболевания у человека.

Ответ:
1. Сколиоз
2. Причина заболевания:
неправильная постановка корпуса при ходьбе / в положении сидя / в положении стоя
ИЛИ
быстрый рост
ИЛИ
сопутствующие нарушения двигательной системы (плоскостопие, рахит, остеохондроз, остеопороз)
ИЛИ
генетическая предрасположенность
Номер: 27250B
Дайте развернутый ответ.
Рассмотрите рисунок, на котором изображены ноги детей с нарушением костеобразования. Как называется заболевание детей раннего возраста, связанное с этим нарушением? При недостатке какого витамина развивается данное заболевание?

Ответ:
1. Рахит
2. Рахит развивается при недостатке витамина D
Номер: 485990
Дайте развернутый ответ.
Рассмотрите рисунок, на котором изображена спина человека с изменённой формой позвоночника. Как называют такое изменение? Какие нарушения в организме вызывает данное изменение формы позвоночника? Укажите два нарушения.

Ответ:
1. Сколиоз
2. Из-за сдавливания внутренние органы и системы перестают нормально функционировать, нарушается пищеварение, работа легких.
Номер: 95A265
Дайте развернутый ответ.
Рассмотрите рисунок с изображением травмированной руки человека. Назовите вид травмы. Объясните, за счёт чего у маленьких детей такие травмы случаются гораздо реже, чем у взрослых людей.

Ответ:
1. Перелом кости верхних конечностей
2. В костных тканях ребенка гораздо больше воды и органических соединений, чем у взрослого человека, и меньше минеральных солей, что обеспечивает меньшую хрупкость костей.
Номер: 8CCA66
Дайте развернутый ответ.
Рассмотрите рисунок с изображением 20-летних мужчин. Как называют отклонение от нормы показателя роста у мужчины, изображённого под номером 1? Приведите одну из причин такого отклонения.

1 2 3
Ответ:
1. Карликовость
2. Возможные причины:
недостаток (нарушение строения) гормона роста (соматотропина)
ИЛИ
нарушение строения и функционирования гипофиза
ИЛИ
недостаток (нарушение строения) гормона щитовидной железы
ИЛИ
патология нейроэндокринной системы
ИЛИ
генетическая предрасположенность (заболевания хрящей, костной и мышечной тканей)
Номер: BDD34C
Дайте развернутый ответ.
Рассмотрите рисунки 1–4 с изображением типов осанок человека. Как называют нарушение осанки, изображённое на рисунке 4? Назовите одну из причин появления такого заболевания у человека.

1 2 3 4
Ответ:
1. Сутулость
ИЛИ
гиперлордоз шейного отдела
2. Причины заболевания: гиподинамия
ИЛИ
неправильная постановка корпуса при ходьбе
ИЛИ
сопутствующие нарушения опорно-двигательной системы (рахит, остеохондроз, остеопороз)
ИЛИ
быстрый рост
ИЛИ
генетическая предрасположенность
Номер: 569143
Дайте развернутый ответ.
Рассмотрите рисунки 1–3, на которых изображены виды наружного кровотечения у человека. Какой сосуд повреждён на рисунке 3? Назовите один из признаков, по которому это можно определить.

1 2 3
Ответ:
1. На рисунке 3 изображено повреждение артерии.
2. Это можно определить по пульсирующему току (иногда фонтану) ярко-алой крови во время артериального кровотечения, в отличие от темной крови из вены, вытекающей ровной струёй или незначительного кровотечения при повреждении капилляров.
Номер: 032E02
Дайте развернутый ответ.
Рассмотрите рисунки 1–3 с изображением реакции мужчины справа (выделен цветом) на ситуацию. Какому типу темперамента соответствует данная реакция? Дайте три характеристики этого типа темперамента.

1 2 3
Ответ:
1. Меланхолик
2. Любые 3 характеристики:
застенчивый, чувствительный, обидчивый, ранимый, мнительный, пессимистичный, рассудительный, слабый, неуравновешенный.
Номер: AB8005
Дайте развернутый ответ.
Рассмотрите рисунки 1–3, иллюстрирующие особенности зрительного восприятия людей с различными видами нарушения зрения. Как называется нарушение зрения, при котором зрительное восприятие человека соответствует рисунку 3? Назовите одну из причин появления такого заболевания у человека.

1 2 3
Ответ:
1. Астигматизм
2. Причина: наследственность. Чаще всего это состояние врожденное, и связано оно с особенностями строения роговицы.
Номер: AA8305
Дайте развернутый ответ.
Рассмотрите рисунки 1–3 с изображением реакции мужчины справа (выделен цветом) на ситуацию. Какому типу темперамента соответствует данная реакция? Дайте три характеристики данного типа темперамента.

1 2 3
Ответ:
1. Тип темперамента: флегматик
2. Любые 3 характеристики:
застенчивый, медлительный, малоподвижный, спокойный, неторопливый, терпеливый, упорный, сильный, уравновешенный, инертный.
Номер: 54627A
Дайте развернутый ответ.
Рассмотрите рисунки 1–3 с изображением реакции мужчины справа (выделен цветом) на ситуацию. Какому типу темперамента соответствует данная реакция? Дайте три характеристики данного типа темперамента.

1 2 3
Ответ:
1. Холерик
2. Любые 3 характеристики:
активный, очень энергичный, настойчивый, легко возбудимый, неуравновешенный, порывистый, воля крепкая
Номер: 0BB5B0
Дайте развернутый ответ.
Рассмотрите рисунок, иллюстрирующий проявление возрастных изменений человека. Как называют совокупность изменений, происходящих в организме человека, которые проиллюстрированы на рисунке? Приведите пример другого внешнего изменения в организме молодого человека, происходящего в это время.

Ответ:
1. Половое созревание (пубертатный период, развитие вторичных половых признаков)
2. Появляются волосы в подмышечных впадинах, в области паха
ИЛИ
огрубение волос по всему телу
ИЛИ
формирование фигуры "мужского типа" (широкие плечи и узкий таз)
ИЛИ
увеличение размера половых органов
ИЛИ
изменение голоса
ИЛИ
изменение запаха пота
Номер: A120B1
Дайте развернутый ответ.
Рассмотрите рисунки 1–3, на которых изображён глаз человека. Какой отдел вегетативной нервной системы контролирует изменение зрачка глаза, изображённого на рисунке 2? Какое изменение в работе пищеварительной системы человека контролирует этот отдел вегетативной нервной системы?

1 2 3
Ответ:
1. Парасимпатический отдел
2. Изменение:
усиливает перистальтику кишечника
ИЛИ
усиливается секреция пищеварительных желез
Номер: 41591F
Дайте развернутый ответ.
Рассмотрите рисунок с изображением схемы функционального деления общей ёмкости лёгких среднестатистического взрослого человека. Как называется объём, обозначенный на рисунке вопросительным знаком? Назовите один из факторов, от которого может зависеть величина этого объёма.

Ответ:
1. Жизненная ёмкость легких
2. зависит от роста
ИЛИ
возраста человека
ИЛИ
рода занятий
Номер: 42AB28
Дайте развернутый ответ.
Рассмотрите рисунки 1–4 с изображением типов осанок человека. Как называют нарушение осанки, изображённое на рисунке 2? Назовите одну из причин появления такого заболевания у человека.

1 2 3 4
Ответ:
1. Нарушение осанки: лордоз (поясничный лордоз, патологический лордоз, гиперлордоз поясничного отдела позвоночника)
2. Причина заболевания: лишний вес (особенно в области живота, в том числе беременность)
ИЛИ
неправильная постановка корпуса при ходьбе / в положении сидя / в положении стоя
ИЛИ
быстрый рост
ИЛИ
сопутствующие нарушения двигательной системы (плоскостопие, рахит, остеохондроз, остеопороз, вывихи тазобедренных суставов)
ИЛИ
генетическая предрасположенность
Номер: 7B9BDA
Дайте развернутый ответ.
Рассмотрите рисунки 1, 2, иллюстрирующие проявление одного из рефлексов человека. Как называют данный рефлекс? С какой целью проверяют наличие этого рефлекса у человека?

1 2
Ответ:
1. Зрачковый рефлекс (сужение зрачка при попадании луча света в глаз (прямая реакция) и координированное сокращение зрачка другого глаза; при удалении источника света зрачки быстро расширяются)
2. Рефлекс используется в диагностике функционального состояния зрительного (II) и глазодвигательного (III) черепномозговых нервов.
Номер: BB3DD6
Дайте развернутый ответ.
Рассмотрите рисунки 1–3, на которых изображены виды наружного кровотечения у человека. Какой сосуд повреждён на рисунке 2? Назовите один из признаков, по которому это можно определить.

1 2 3
Ответ:
1. На рисунке 2 изображено повреждение вены.
2. Это можно определить по тому, что темная кровь вытекает ровной струёй, в отличие от пульсирующего тока (иногда фонтана) ярко-алой крови во время артериального кровотечения (на третьем рисунке) или незначительного выделения крови при капиллярном кровотечении (рисунок 1).
Номер: 29CCDD
Дайте развернутый ответ.
Рассмотрите рисунки 1–3, иллюстрирующие особенности зрительного восприятия людей с различными видами нарушения зрения. Как называют нарушение зрения, при котором зрительное восприятие человека соответствует рисунку 2? Назовите одну из причин появления такого заболевания у человека.

1 2 3
Ответ:
1. Нарушение зрения: дальнозоркость (гиперметропия)
2. Причина заболевания: возраст (младенческая/старческая дальнозоркость)
ИЛИ
генетическая предрасположенность
Номер: 53AEDB
Дайте развернутый ответ.
Рассмотрите рисунок с изображением схемы функционального деления общей ёмкости лёгких среднестатистического взрослого человека. Как называется объём, обозначенный на рисунке вопросительным знаком? Какую функцию он выполняет?

Ответ:
1. Жизненная ёмкость легких
2. Это максимальный объем воздуха, который может быть набран в легкие после полного выдоха. При большой жизненной ёмкости лёгкие лучше вентилируются, и организм получает больше кислорода.
Номер: A359D4
Дайте развернутый ответ.
Рассмотрите рисунок, иллюстрирующий проявление возрастных изменений человека. Как называется совокупность изменений, происходящих в организме человека, которые проиллюстрированы на рисунке? Приведите пример другого внешнего изменения организма девушки, происходящего в это время.

Ответ:
1. Половое созревание (пубертатный период, развитие вторичных половых признаков)
2. Появляются волосы в области паха
ИЛИ
рост молочных желез
ИЛИ
формирование фигуры "женского типа" (широкие бедра, выпуклая грудь)
Номер: 21F9A5
Дайте развернутый ответ.
Рассмотрите рисунки 1–3, на которых изображён глаз человека. Какой отдел вегетативной нервной системы контролирует изменение зрачка глаза, изображённого на рисунке 3? Какое изменение в работе органов кровеносной системы человека контролирует этот отдел вегетативной нервной системы?

1 2 3
Ответ:
1) Симпатический отдел.
2) Изменение: ускорение (усиление) сердцебиения
ИЛИ
сужение сосудов
ИЛИ
повышение артериального давления
Номер: 6FCDCF
Дайте развернутый ответ.
Рассмотрите рисунок, иллюстрирующий проявление возрастных изменений человека. Как называют совокупность изменений, происходящих в организме человека, которые проиллюстрированы на рисунке? Приведите пример другого внешнего изменения организма девушки, происходящего в это время.

Ответ:
1. Половое созревание (пубертатный период, развитие вторичных половых признаков)
2. Появляются волосы в области паха и подмышек
Номер: 3CD6E6
Дайте развернутый ответ.
Рассмотрите рисунки 1–4 с изображением типов осанок человека. Как называют нарушение осанки, изображённое на рисунке 3? Назовите одну из причин появления такого заболевания у человека.

1 2 3 4
Ответ:
1. Кифоз грудного отдела позвоночника (гиперкифоз)
2. Причина заболевания: лишний вес
ИЛИ
неправильная постановка корпуса при ходьбе / в положении сидя / в положении стоя
ИЛИ
быстрый рост
ИЛИ
сопутствующие нарушения двигательной системы (плоскостопие, рахит, остеохондроз, остеопороз)
ИЛИ
генетическая предрасположенность
Номер: F0363A
Дайте развернутый ответ.
Рассмотрите рисунок с изображением 20-летних мужчин. Как называют отклонение от нормы показателя роста у мужчины, изображённого под номером 2? Приведите одну из причин такого отклонения.

1 2 3
Ответ:
1. Гигантизм
2. Возможные причины:
избыток гормона роста (соматотропина)
ИЛИ
нарушение работы гипофиза
ИЛИ
патология нейроэндокринной системы
ИЛИ
нейроинфекции (энцефалит, менингит)
ИЛИ
генетическая предрасположенность.
Растения и животные
Дайте развернутый ответ.
Мучной хрущак — это один из вредителей, обитающих рядом с человеком. Взрослые особи и личинки питаются мукой, манной крупой, отрубями. Они также способны портить запасы гречневой крупы, риса и сухофруктов. На рисунке представлены мучной хрущак и график, отражающий пределы выносливости по температуре для развития личинок и взрослых особей. К какому классу относят это животное? Предложите одну из мер борьбы с мучным хрущаком, исходя из данных, представленных на графике.

Ответ:
1. Класс насекомые
2. Продукты, которыми питается мучной хрущак, нужно хранить при низких температурах, максимально близких к 0 градусов по Цельсию.
Номер: 9CF501
Дайте развернутый ответ.
Для получения хорошего урожая томатов садоводы проводят пасынкование. Рассмотрите рисунок, на котором отображён этот агротехнический приём, и опишите, в чём он заключается. Почему пасынкование повышает урожайность томатов?

Ответ:
1. Пасынкование заключается в удалении боковых побегов.
2. Процедура пасынкования улучшает приток питательных веществ к плодам и листьям, ускоряет созревание урожая, увеличивает размер и массу плодов.
Номер: 91D2DE
Дайте развернутый ответ.
Баклажан — популярная овощная культура. Рассмотрите рисунок, на котором показаны условия выращивания и продолжительность вегетационного периода баклажана. Почему в нашей стране эту культуру высаживают в почву рассадой, а не семенами, как, например, репу или свёклу? Укажите две причины.

Ответ:
Вегетационный период баклажана 120-150 дней, это 4-5 месяцев.
В большинстве регионов нашей страны не может быть оптимальных условий выращивания баклажанов в открытом грунте на протяжении всех пяти месяцев, потому что:
- температура почвы весной и осенью менее +17 градусов,
- световой день менее 16 часов,
- температура воздуха менее +20 градусов.
Номер: C96757
Дайте развернутый ответ.
Томат — популярная овощная культура. Рассмотрите рисунок, на котором показаны условия выращивания и продолжительность вегетационного периода томата. Почему в нашей стране эту культуру высаживают в почву рассадой, а не семенами, как, например, репу или свёклу? Укажите две причины.

Ответ:
Вегетационный период баклажана 120-150 дней, это 4-5 месяцев.
В большинстве регионов нашей страны не может быть оптимальных условий выращивания баклажанов в открытом грунте на протяжении всех пяти месяцев, потому что:
- температура почвы весной и осенью менее +17 градусов,
- световой день менее 16 часов,
- температура воздуха менее +20 градусов.
Номер: D655E4
Дайте развернутый ответ.
Пищевая моль — это один из вредителей, обитающих рядом с человеком. Личинки питаются крупами, макаронами, печеньем, орехами и сухофруктами. На рисунке представлены пищевая моль и график, отражающий пределы выносливости по температуре для развития личинок. К какому классу относят это животное? Предложите одну из мер борьбы с пищевой молью, исходя из данных, представленных на графике.

Ответ:
1. Класс насекомые
2. Продукты, которыми питается пищевая моль, нужно хранить при низких температурах, максимально близких к -10 градусам по Цельсию.
Номер: 742933
Дайте развернутый ответ.
Рассмотрите схему цикла развития паразитического червя. Укажите название этого червя. Каким хозяином для данного паразита может стать человек? Ответ поясните.

Ответ:
1. Печеночный сосальщик
2. Человек может стать основным хозяином этого паразита, так как в желчных протоках печени человека может происходить его половое размножение.
Номер: 927030
Дайте развернутый ответ.
Рассмотрите схему цикла развития паразитического червя. К какому типу относят этого червя? Какие две меры профилактики заражения данным червём следует соблюдать?

Ответ:
1. Острицы – это паразитические круглые черви.
2. Меры профилактики: мыть руки перед едой, после посещения туалета и контакта с животными
ИЛИ
не грызть ногти на руках
ИЛИ
частая замена постельного белья, полотенец, предметов гигиены
ИЛИ
влажная уборка с дизинфицирующими средствами
ИЛИ
стирка постельного и нательного белья в горячей воде с последующим проглаживанием или отпариванием
Номер: 5FE285
Дайте развернутый ответ.
Рассмотрите рисунок с изображением моллюска. К какому классу относят этого моллюска? С какой целью моллюсков этого класса подселяют в аквариумы с рыбами и растениями?

Ответ:
1. Класс брюхоногие моллюски
2. Улитки подбирают со дна и из труднодоступных мест остатки пищи, выполняя роль чистильщиков;
улитки поедают подгнивающие части растений и ненужные водорослевые обрастания;
улитки могут служить индикатором химического состава воды (например, при снижении кислорода в воде они поднимаются к поверхности)
Номер: 2D63FD
Дайте развернутый ответ.
Рассмотрите рисунки 1, 2 с изображением домашних животных. Какое заболевание через укус может распространять животное, изображённое на рисунке 2? Сформулируйте порядок действия пострадавшего от укуса данным животным?

1 2
Ответ:
1. Собака может распространять через укус бешенство.
2. Промойте рану перекисью водорода или обильным количеством воды, окружность раны смажьте йодом, наложите чистую повязку. Выясните у хозяев (если таковые присутствуют), сделана ли собаке прививка от бешенства.
Обратитесь в ближайший травмпункт для получения квалифицированной медицинской помощи.
Номер: AC47FB
Дайте развернутый ответ.
Рассмотрите рисунки 1–4, на которых изображены некоторые этапы пересадки молодого растения. Как называют агротехнический приём, изображённый на рисунках 1 и 2? С какой целью он используется?

1 2 3 4
Ответ:
1. Прием: пикировка (пикировка корня)
ИЛИ
прищипка (удаление) верхушки главного корня
2. Цель: увеличение количества и силы боковых корней (увеличение ветвления корневой системы)
ИЛИ
увеличение площади почвенного питания растения (сосредоточение корней в верхнем плодородном слое почвы
ИЛИ
улучшение приживаемости растения при пересадке
Номер: 63F3F1
Дайте развернутый ответ.
Рассмотрите рисунки 1, 2, на которых изображены соответственно самец и самка паразитического червя. Как называют данного червя? Назовите одну из мер предосторожности, которую необходимо соблюдать человеку, чтобы не заразиться этим паразитом?

1 2
Ответ:
1. Название червя: аскарида
2. Меры предосторожности: мыть руки перед едой, после посещения туалета и контакта с животными
ИЛИ
не грызть ногти на руках
ИЛИ
частая замена постельного белья, полотенец, предметов гигиены
ИЛИ
влажная уборка с дизинфицирующими средствами
ИЛИ
Стирка постельного и нательного белья в горячей воде с последующим проглаживанием или отпариванием
Номер: 74050D
Дайте развернутый ответ.
Рассмотрите рисунок с изображением одомашненного насекомого. Как называют насекомое, изображённое на рисунке? Какую пользу получает человек от этого насекомого?

Ответ:
1. Тутовый шелкопряд
2. Польза: получение шелковой нити
Номер: BD667B
Дайте развернутый ответ.
Рассмотрите рисунки 1, 2 с изображением процессов жизнедеятельности растения. Как называют процесс, изображённый на рисунке 2? Сформулируйте одно из правил по уходу за комнатными растениями с учётом знания этого процесса?

Ответ:
1. Процесс: дыхание
2. Правило: с поверхности всех органов (листьев и стеблей) нужно регулярно аккуратно стирать пыль (так как дишит растение с помощью устьиц и чечевичек)
ИЛИ
необходимо регулярно рыхлить почву в горшке (для лучшего доступа кислорода к клеткам корней)
ИЛИ
необходимо проветривать помещение (так как днем растения дышат в основном атмосферным кислородом)
ИЛИ
необходимо обеспечить комнатным растениям условия для фотосинтеза (так как ночью растения дышат в основном запасенным в межклетниках фотосинтетическим кислородом)
Номер: 12997D
Дайте развернутый ответ.
Рассмотрите рисунок с изображением одомашненного насекомого. Как называют насекомое, изображённое на рисунке? Какую пользу получает человек от этого насекомого? Назовите одну из них.

Ответ:
1. Пчела
2. Польза:
получение меда
ИЛИ
получение воска
ИЛИ
получение маточного молочка
ИЛИ
получение перги
Номер: 23B47E
Дайте развернутый ответ.
Рассмотрите рисунки 1–3, на которых изображены соответственно членик, головка и общий план строения паразитического червя. К какому классу относят данного червя? Какую меру предосторожности необходимо соблюдать человеку, чтобы не заразиться этим паразитом?

1 2 3
Ответ:
1) Свиной цепень
ИЛИ
свиной солитер
2) Мера предосторожности: не есть сырое (непроваренное или непрожаренное) мясо свиньи
ИЛИ
подвергать мясо длительной термической обработке
Номер: D5227B
Дайте развернутый ответ.
Рассмотрите рисунки 1, 2 с изображением процессов жизнедеятельности растения. Как называют процесс, изображённый на рисунке 1? Сформулируйте одно из правил по уходу за комнатными растениями с учётом знания этого процесса?

Ответ:
1. Процесс: фотосинтез
2. Правило: комнатное растение долно быть достаточно освещено (в зависимости от его требовательности к интенсивности и продолжительности освещения)
ИЛИ
с поверхности фотосинтезирующих органов (листьев и стеблей) нужно регулярно аккуратно стирать пыль
ИЛИ
для фотосинтеза необходима вода, поэтому растение необходимо достаточно поливать (в зависимости от его требовательности к интенсивности и способу)
Номер: E9BF73
Дайте развернутый ответ.
Рассмотрите рисунки 1, 2, иллюстрирующие способы вегетативного размножения растений. Как называют способ вегетативного размножения, изображённый на рисунке 1? В чём заключается преимущество такого способа размножения растений по сравнению со способом, изображённым на рисунке 2.

1 2
Ответ:
1) способ размножения: размножение клубнями (размножение частями клубня);
2) преимущество: в быстром росте и развитии побега, так как в частях клубня содержится запас питательных веществ;
ИЛИ
в получении одновременно нескольких побегов, так как на части клубня может оказаться несколько глазков gdzotvet.ru
Номер: 75A6B5
Дайте развернутый ответ.
Рассмотрите рисунок, иллюстрирующий один из способов вегетативного размножения комнатного растения. Как называют этот способ размножения растения? Сформулируйте одно из правил, которым должен руководствоваться человек, использующий такой способ размножения растения.

Ответ:
1. Способ размножения: размножение черенками (размножение листовыми черенками)
2. Правило:
выбор растения, способного к такому размножению
ИЛИ
выбор здорового (неповрежденного) листа (с длинным черешком)
ИЛИ
добавление в воду стимулятора корнеобразования
ИЛИ
поддержание комнатной температуры воды и воздуха
ИЛИ
поддержание уровня воды
ИЛИ
своевременная высадка укоренившегося листа в горшок
Номер: 61C7B4
Дайте развернутый ответ.
Рассмотрите рисунок, на котором изображён взрослый паразитический червь. Как называют данного червя? Назовите одну из мер предосторожности, которую необходимо соблюдать человеку, чтобы не заразиться этим паразитом?

Ответ:
1. Печеночный сосальщик
2. Мера предосторожности: не пить сырую нефильтрованную воду
ИЛИ
не брать в рот травинки по берегам водоемов
Номер: AEAA1A
Дайте развернутый ответ.
Рассмотрите рисунки 1–5, на которых изображены некоторые этапы пересадки молодого растения. Как называют агротехнический приём, изображённый на рисунке 2? С какой целью применяется заострённый колышек – пика?

Ответ:
1. Приём: пикировка (пикировка корня)
ИЛИ
прищипывание главного корня
2. Цель применения пики: уплотнение почвы вокруг корня
ИЛИ
формирование лунки для пересадки растения
Номер: A5DA16
Дайте развернутый ответ.
Рассмотрите рисунок с изображением агротехнического приёма, используемого при выращивании рассады. Как называют приём, изображённый на рисунке? С какой целью он используется?

Ответ:
1) Приём: рассаживание рассады
ИЛИ
пикировка (пикировка корня);
2) Цель: увеличение объёма почвы (увеличение объёма собственного почвенного кома) для лучшего закрепления и питания
ИЛИ
улучшение приживаемости растения при дальнейшей пересадке в открытый грунт или в теплицу (отсутствие переплетения корней с соседними растениями)
ИЛИ
увеличение количества и силы боковых (придаточных) корней (увеличение ветвления корневой системы) для увеличения площади питания растения
Номер: 4950DE
Дайте развернутый ответ.
Рассмотрите рисунок, на котором изображена аквариумная рыба. В чём особенность строения её системы дыхания по сравнению с хрящевыми рыбами? Какое значение для рыб этого класса имеет установка в аквариумах системы подачи воздуха?

Ответ:
1. Это представитель класса Костные рыбы, а костные рыбы дышат жарами, которые прикрыты жаберными крышками (в отличие от хрящевых), поэтому процесс газообмена несколько затруднён.
2. Установка в аквариумах системы подачи воздуха улучшает аэрацию воды, насыщает её кислородом, процесс дыхания у рыб становится более эффективным.
Номер: 016FDB
Дайте развернутый ответ.
Рассмотрите рисунок, на котором изображена акула. В чём особенность строения её системы дыхания по сравнению с костными рыбами? Какое значение для рыб этого класса имеет установка в небольших океанариумах насосов для создания водного течения?

!Ответ:
1. Особенности: отсутствие жаберных крышек, пять жаберных отверстий
2. Значение: обеспечение тока воды с растворенным кислородом в жабрах
ИЛИ
У акул них нет жаберных крышек, жаберные щели открываются непосредственно в воду. Чтобы создать поток воды через жабры, акула вынуждена все время плавать, пропуская воду через рот и выпуская через жаберные щели. Если акула не будет двигаться, она погибнет. Установка в небольших океанариумах насосов для создания водного течения позволяет не допустить гибели акул.
Номер: C251D6
Дайте развернутый ответ.
Рассмотрите рисунок с изображением агротехнического приёма. Как называется этот приём? С какой целью он используется при выращивании декоративно цветущих растений?

Ответ:
1. Прием: прищипывание (прищипывание верхушки побега)
2. Цель: ограничение вертикального роста
ИЛИ
увеличение количества и силы боковых побегов (увеличение ветвления)
Номер: ED0EDB
Дайте развернутый ответ.
Рассмотрите рисунки 1, 2 с изображением домашних животных. Какое заболевание, опасное для человека, особенно для беременных женщин, может распространять животное, изображённое на рисунке 1? Приведите одну из мер предосторожности, которую рекомендуется соблюдать человеку, чтобы избежать заражения?

1 2
Ответ:
1. Кошка может распространять токсоплазмоз
2. Меры предосторожности: избегать укусов и царапин кошек
Номер: 496750
Дайте развернутый ответ.
Рассмотрите рисунок с изображением паразитического простейшего. Какое заболевание развивается у человека при заражении простейшим, изображённым на рисунке? Назовите одно из правил, которого следует придерживаться человеку для профилактики заражения данным заболеванием.

Ответ:
1. Заболевание: сонная болезнь
ИЛИ
трипаносомоз
2. Правило: не посещать территории распространения заболевания (в Африке)
ИЛИ
носить светлую закрытую одежду для защиты от укуса мухи цеце
ИЛИ
проводить профилактическое введение соответствующего лекарства
Номер: 53CE92
Дайте развернутый ответ.
Рассмотрите рисунок с изображением агротехнического приёма. Как называют приём, изображённый на рисунке? С какой целью он используется?

Ответ:
1. Рыхление
2. Цель рыхления - это нарушение естественных ходов в почве для влагоиспарения. Частое рыхление способствует лучшему проникновению кислорода, циркуляции воздуха в поверхностном слое, оседанию воздушной влаги за счет конденсации паров. Сокращается потребность в поливах, подавляется рост сорняков.
Номер: 97D59A
Дайте развернутый ответ.
Рассмотрите рисунок с изображением раковин моллюсков. К какому классу относят моллюска, имеющего раковину, изображённую на рисунке 2? Назовите одно из значений моллюсков этого класса в жизни человека.

1 2
Ответ:
1. Моллюска относят к классу двустворчатых моллюсков.
2. Значение: употребление в пищу
ИЛИ
фильтруют воду в водоемах и способствуют ее очищению
ИЛИ
изготовление украшений
Номер: 9A9D9C
Дайте развернутый ответ.
Рассмотрите рисунок с изображением агротехнического приёма. Как называют этот приём? С какой целью он используется?

Ответ:
1. Прием: прищипывание (прищипывание верхушки побега)
2. Цель: ограничение вертикального роста
ИЛИ
увеличение количества и силы боковых побегов (увеличение ветвления)
Номер: 6B28EA
Дайте развернутый ответ.
Рассмотрите рисунок с изображением червя. Как называют данного представителя кольчатых червей? Назовите одно из значений этого червя в природе.

Ответ:
1. Дождевой червь
2. Значение: аэрация почвы
ИЛИ
улучшение структуры почвы и повышение ее плодородия
ИЛИ
служат кормом для других животных
Номер: 2A9632
Дайте развернутый ответ.
Рассмотрите рисунки 1, 2 с изображением видоизменённых корней моркови. Как называют данное видоизменение корня? Какой агротехнический приём необходимо использовать человеку для снижения вероятности деформации корня моркови, изображённого на рисунке 1?

1 2
Ответ:
1. Видоизменение: корнеплод
2. Прием: качественное рыхление почвы (перед посадкой)
ИЛИ
удаление из почвы крупных камней
ИЛИ
удаление из почвы крупных сорняков
Номер: 907D3F
Дайте развернутый ответ.
Рассмотрите рисунок с изображением паразитического простейшего. Какое заболевание развивается у человека при заражении простейшим, изображённым на рисунке? Назовите одно из правил, которого следует придерживаться человеку для профилактики заражения данным заболеванием.

Ответ:
1. У человека при заражении лямблией развивается лямблиоз.
2. Тщательное мытьё рук перед едой
ИЛИ
не пить сырую нефильтрованную воду
ИЛИ
мыть перед употреблением фрукты, овощи, ягоды и зелень
ИЛИ
закрывать еду от насекомых
ИЛИ
соблюдать правила личной гигиены.
Номер: 18098B
Дайте развернутый ответ. 2025
Рассмотрите рисунок, иллюстрирующий один из способов вегетативного размножения растения. Как называют этот способ вегетативного размножения? В чём заключается один из недостатков такого способа размножения растения по сравнению с размножением семенами.

Ответ:
Вегетативное размножение отводками. Недостатки вегетативного размножение по сравнению с размножением семенами: при многократном повторении вегетативного размножения происходит «старение» растения. Это снижает его устойчивость к условиям среды и болезням.
Номер: 5B8F97
2026 год
Дайте развернутый ответ.
Рассмотрите рисунки 1 и 2, на которых представлены хромосомные наборы человека. Какому полу принадлежат эти наборы? Какие особенности будут у организма с хромосомным набором, представленным на рисунке 2, по сравнению с обладателем хромосомного набора на рисунке 1?


1 2
Ответ:
Последняя пара (23) XY определяет мужской пол.
На втором рисунке у организма с таким набором хромосом будет синдром Дауна (трисомия 21).
Номер: 8807D0
Дайте развернутый ответ.
Рассмотрите хромосомный набор человека. Какому полу принадлежит этот набор? Есть ли отклонения от нормы? Ответ поясните.

Ответ:
Женский пол (последняя пара хромосом ХХ).
Есть. У организма с таким набором хромосом будет синдром Дауна (трисомия 21), потому что в кариотипе присутствует три 21-е хромосомы.
Номер: 590ECA
Дайте развернутый ответ.
Рассмотрите рисунки 1–4 с изображением зуба человека. Как называют заболевание зубов, стадии развития которого отображены на рисунках 1–3? Назовите одну из причин появления такого заболевания у человека.

1 2 3 4
Ответ:
На изображении показаны стадии развития кариеса и его осложнений.
Начальный кариес: разрушение эмали зуба.
Действительный кариес: поражение дентина под эмалью.
Пульпит: инфекция достигает пульпы (нерва) зуба.
Периодонтит/Абсцесс: инфекция распространяется за пределы корня, образуя воспаление или кисту.
Одной из основных причин появления кариеса у человека является воздействие кислот, вырабатываемых бактериями в зубном налете при расщеплении сахаров и углеводов из пищи, например при несоблюдении гигиены полости рта.
ОФИЦИАЛЬНЫЕ КЛЮЧИ:
Заболевание зуба: кариес или пульпит.
Причина заболевания: плохая гигиена полости рта (некачественная чистка зубов, нерегулярные профилактические осмотры у стоматолога),
ИЛИ несбалансированное питание,
ИЛИ некачественная питьевая вода,
ИЛИ генетическая предрасположенность,
ИЛИ сопутствующие заболевания органов пищеварительной системы (а также дыхательной, эндокринной и иммунной систем).
Номер: 4A2AEA
Дайте развернутый ответ.
Рассмотрите микрофотографии 1 и 2 с образцами крови лягушки и человека. Определите, какой образец крови лягушки, а какой человека. На основании изучения представленных образцов, объясните, почему кровь человека может переносить больше кислорода. Приведите два доказательства.

1 2
Ответ:
На рисунке 1 — кровь человека: эритроциты мелкие, имеют форму двояковогнутых дисков и не содержат ядра. 2 — кровь лягушки: эритроциты крупные, овальной формы и имеют ядро.
Зрелые эритроциты человека утрачивают ядро, что увеличивает внутренний объем клетки, доступный для заполнения гемоглобином. Чем больше гемоглобина может вместить клетка, тем больше кислорода она способна связать и транспортировать.
Двояковогнутая форма эритроцитов человека создает большую площадь поверхности клетки по отношению к ее объему. Это обеспечивает более быструю и эффективную диффузию кислорода через мембрану клетки. Эритроциты лягушки имеют овальную форму, что снижает эффективность газообмена.
Номер: 78FE60
Дайте развернутый ответ.
На пакетиках с семенами часто схематично указывают агротехнику посева и выращивания данного растения. Рассмотрите рисунки с элементами агротехники редиса. На какую глубину следует заделывать семена? От чего зависит этот показатель? Какой элемент агротехники отображён на рисунке 4?

Ответ:
1) 1-2 см
2) Глубина заделки семян зависит от следующих факторов
-
Размер семян. Это главный фактор. Крупные семена (горох, фасоль, тыква) сеют глубже, так как в них больше запас питательных веществ, позволяющий ростку пробиться с большой глубины. Мелкие семена (редис, морковь, салат) сеют мелко, почти поверхностно, так как их силы хватит только на преодоление небольшого расстояния в верхнем, хорошо прогреваемом слое почвы.
-
Тип и влажность почвы.
-
На легких песчаных и супесчаных почвах семена сеют немного глубже, так как такие почвы быстро просыхают сверху, и влага для набухания семени сохраняется только в более глубоких слоях.
-
На тяжелых глинистых почвах семена сеют мельче, так как глина плотная, содержит много влаги, но плохо пропускает воздух. Глубоко посаженное семя может задохнуться или не пробить твердую корку.
-
-
Время посева и климат. При ранневесеннем посеве, когда почва влажная и прохладная, семена можно сеять чуть мельче. При летнем посеве (в сухую погоду) глубину слегка увеличивают, чтобы достать до влажного слоя, или же обильно проливают бороздки перед посадкой.
3) Элемент агротехники называется схема посадки или схема посева. В агротехнике такой рисунок обозначает площадь питания растения, то есть ту площадь почвы, которая необходима одному растению для нормального роста, развития и получения корнеплодом товарного размера.
Номер: 84320C
Дайте развернутый ответ.
Рассмотрите рисунки 1 и 2 с изображением членистоногих. Назовите этих членистоногих. Каково значение в жизни человека животного, изображённого на рисунке 2?


1 2
Ответ:
На рисунке 1 клещ, на 2 - таракан (рыжий таракан - прусак).
Преимущественно отрицательное. Тараканы — синантропные вредители: они портят и заражают продукты, переносят возбудителей опасных заболеваний (дизентерия, сальмонеллез) и яйца гельминтов, а также являются сильными аллергенами.
Номер: 3AC5C7
Дайте развернутый ответ.
Рассмотрите рисунки 1 и 2 с изображением паразитических членистоногих. На каком рисунке изображён постельный клоп? Чем опасны укусы постельного клопа для человека? Приведите два аргумента.


Ответ:
Постельный клоп изображён на рисунке 2.
Опасность укусов постельного клопа для человека (два аргумента):
-
Аллергические реакции. В слюне клопа содержатся белки, вызывающие у человека сильный зуд, покраснение и обширные отёчные волдыри (уртикарная сыпь). При множественных укусах и повышенной чувствительности может развиться тяжёлая аллергическая реакция, вплоть до анафилактического шока или присоединения вторичной инфекции из-за расчёсов.
-
Нарушение сна и психологический дискомфорт. Постельные клопы ведут ночной образ жизни. Их постоянные нападения, зуд и ощущение ползающих по телу насекомых лишают человека нормального сна, что приводит к хронической усталости, раздражительности, снижению работоспособности и развитию неврозов (бессонница, тревожность).
Номер: 8845C4

